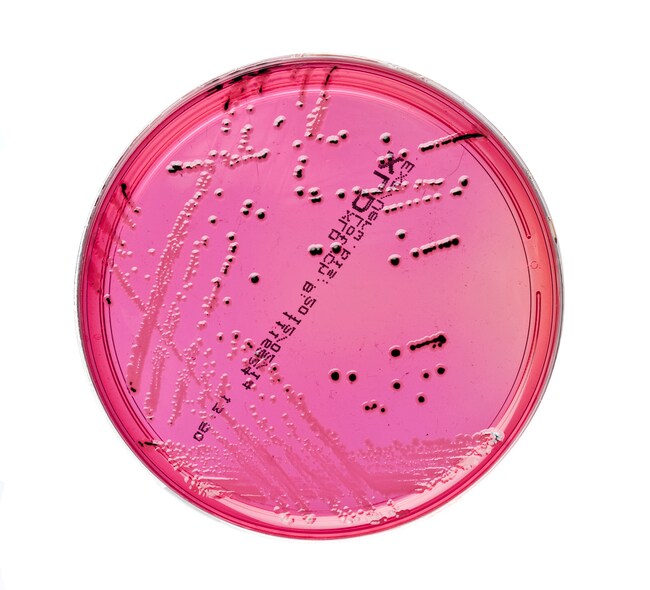
XLD Agar

Search
Thermo Scientific™
XLD Agar
Isolate and identify Salmonella and Shigella spp. with a selective medium that relies on xylose fermentation, lysine decarboxylation and production of hydrogen sulphide.
| 货号 | 数量 | 产品规格 | 培养基类型 | 原料来源 |
|---|---|---|---|---|
| PO0164A | 10/Pk. | 90mm Monoplate | XLD Agar | 英国 |
货号 PO0164A
价格(CNY)
-
数量:
10/Pk.
产品规格:
90mm Monoplate
培养基类型:
XLD Agar
原料来源:
英国
Isolate and identify Salmonella and Shigella spp. with Thermo Scientific™ XLD Agar, a selective medium that relies on xylose fermentation, lysine decarboxylation and production of hydrogen sulphide for the primary differentiation of shigellae and salmonellae from non-pathogenic bacteria.
XLD Agar is a selective media for the isolation and differentiation of Salmonella, relying on xylose fermentation, lysine decarboxylation and production of hydrogen sulfide for the primary differentiation of Shigella and Salmonella spp. from non-pathogenic bacteria. The sensitivity and selectivity of XLD Agar exceeds that of traditional plating media, e.g., Eosin Methylene Blue and Bismuth Sulphite agars, which tend to suppress the growth of shigellae. The recovery of salmonellae and shigellae is not obscured by profuse growth of other species; therefore, XLD Agar is ideal for the screening of samples containing mixed flora and suspected of harbouring enteric pathogens, e.g., medical specimens or food products. XLD Agar is recommended in the ISO 6579 testing of Salmonella and is tested according to ISO 11133-2.
Salmonella and Shigella are major causes of bacterial enteric illness with transmission occuring via the fecal-oral route, person-to-person contact, or by the ingestion of contaminated food or water. A relatively small number of organisms ingested is capable of causing symptomatic infection. Salmonella and Shigella are aerobic, gram-negative, oxidase-negative bacilli. Some Salmonella and all Shigella are non-motile.
This media is tested according to ISO 11133-2 and is recommended in the ISO 6579 for testing of Salmonella.
Not all products are available for sale in all territories. Please inquire.
Remel™ and Oxoid™ products are now part of the Thermo Scientific brand, combining powerful manual, semi-automated and fully automated test products and a comprehensive line of media and diagnostic products to offer a complete, end-to-end solution to quickly deliver the products you need and the quality results your laboratory depends on.
Salmonella and Shigella are major causes of bacterial enteric illness with transmission occuring via the fecal-oral route, person-to-person contact, or by the ingestion of contaminated food or water. A relatively small number of organisms ingested is capable of causing symptomatic infection. Salmonella and Shigella are aerobic, gram-negative, oxidase-negative bacilli. Some Salmonella and all Shigella are non-motile.
This media is tested according to ISO 11133-2 and is recommended in the ISO 6579 for testing of Salmonella.
Not all products are available for sale in all territories. Please inquire.
Remel™ and Oxoid™ products are now part of the Thermo Scientific brand, combining powerful manual, semi-automated and fully automated test products and a comprehensive line of media and diagnostic products to offer a complete, end-to-end solution to quickly deliver the products you need and the quality results your laboratory depends on.
规格
认证/合规Tested in accordance with CEN ISO/TS 11133-2. According ISO 6579
颜色Red, clear
容纳重量19.5g ± 1.0g
产品规格90mm Monoplate
培养基类型XLD Agar
包装类型Flow Wrapped - Single Layer
数量10/Pk.
有效期14 Weeks
原料来源英国
产品类型Agar Plate
Unit SizeEach
内容与储存
2°C to 10°C